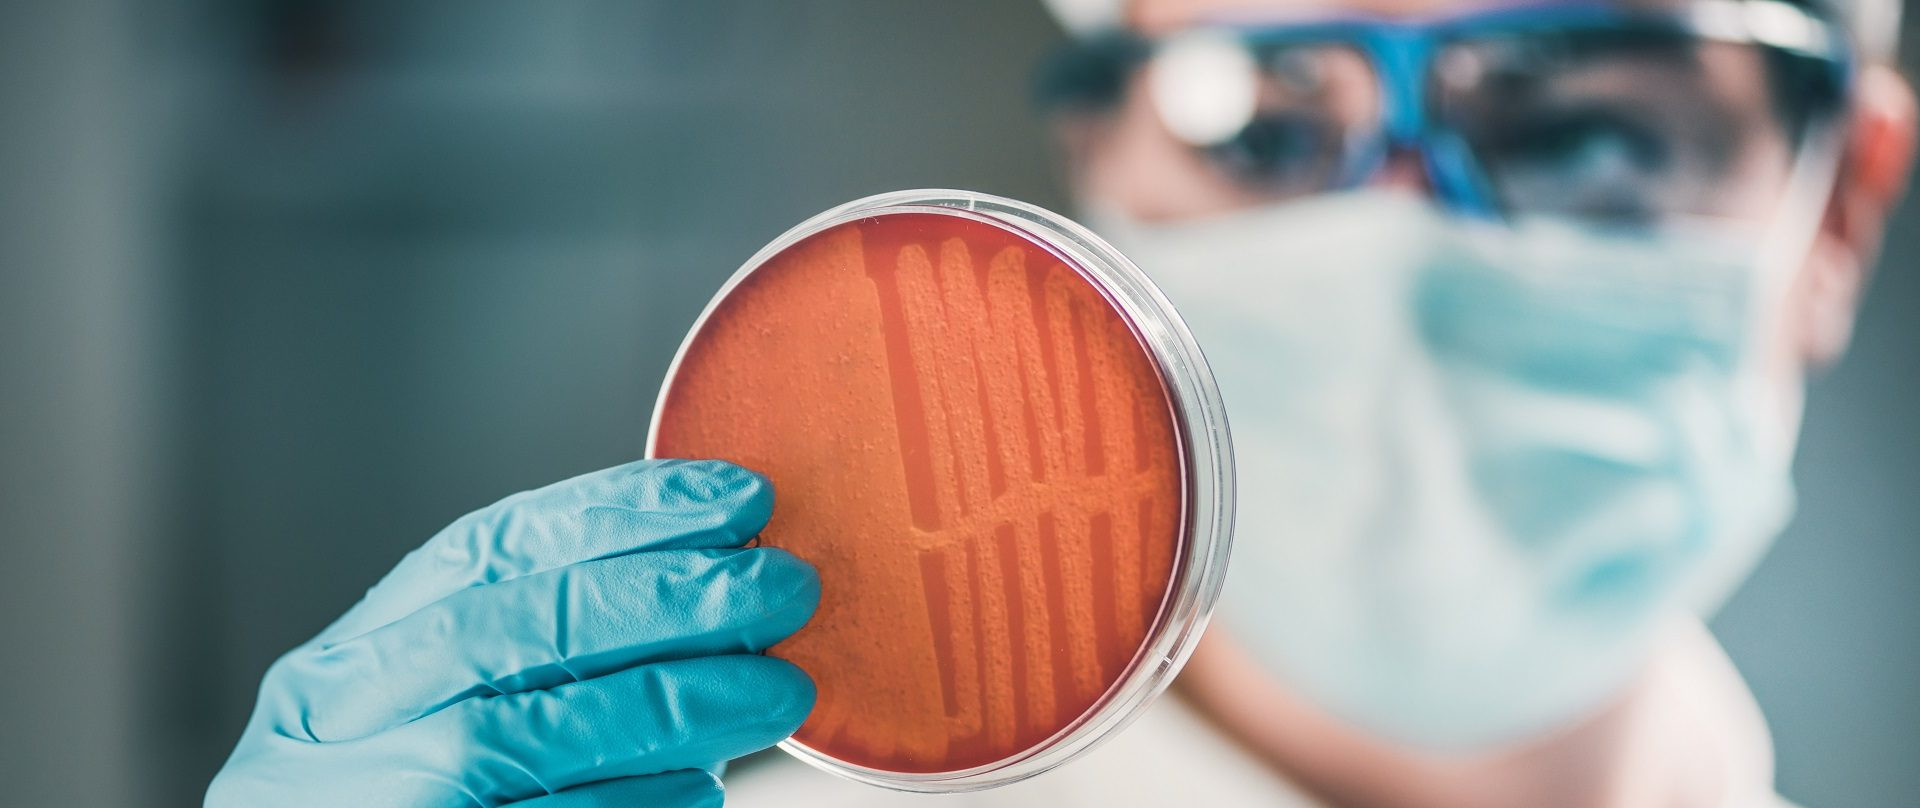

New Iran Conflict layer on GlobeView
We’ve launched a new Iran Conflict layer on GlobeView, giving users a single, intuitive view of key insights on the rapidly evolving situation in the Persian Gulf.
More info to be added over time.
This is archived. This content was originally published on nepia.com or standard-club.com and will no longer be updated. Please check our live news area for all our latest updates.
Biofuels enter the sustainable fuel mix
Achieving the IMO’s goals on greenhouse gas emissions will require a shift in how vessels are fueled and propelled. Amongst the options available to shipowners on meeting the IMO targets, lower-carbon fuels are likely to be a popular option – one of which is biofuels.
Switching to biofuels could be an attractive proposition to some shipowners. The conversion to biofuels – whether a blend or ‘drop-in’ (replacement) fuel – is relatively simple. Ships’ engines and transfer and storage systems will require minimal modifications from using traditional marine (fossil) fuel. The lack of availability and higher costs have been identified as barriers to adoption, but there could be positive shifts in this area too.
North has already received enquiries from shipowners who are considering using biofuels, indicating interest is growing and the shipping industry is keen to know more. We spoke to Bart Hellings and Johannes Schurmann from biofuel provider GoodFuels based in the Netherlands for expert insight.
How do biofuels compare with fossil fuels?
Just like fossil fuels there are multiple types of biofuels and they can also differ on sulphur, density, and viscosity parameters. The heaviest marine biofuel which GoodFuels supply is MR1-100 which compares to RMD-80. Different biofuels which are closer to other product categories are also available.
How does ISO 8217:2017 cater for the latest biofuels?
It’s important to remember that ISO 8217 is a fossil fuel standard; and while it could be used as a guideline, there are missing parameters that are relevant to biofuels and others which are no longer relevant.
Are biofuels susceptible to microbial growth and what about their shelf life?
They normally contain less than 0.05% (v/v) water which is very low. Microbial growth normally occurs when water is added to the fuel by condensation or poor housekeeping on the ship. This risk is reduced by storing in a clean fuel tank and preventing water ingress. Special additives have been developed if microbial activity is a concern and specific operational procedures will be required.
Some biofuels undergo processes where oxygen is eliminated and are perhaps even more resistant to microbial growth in terms of quality and have at least the same shelf life of fossil fuels.
How is quality of the biofuel assured?
Poor quality biofuels can be very diverse in their content and characteristics. GoodFuels have found that the following helps with the overall quality:
Large portfolio of quality, long-term and stable supply partners
Use of special additives
Proven recipes based on five years of continuous testing which results in consistent quality – especially for higher blends
How is biofuel quality and conformity proven?
A certificate of analysis (CoA) will confirm that specifications have been met and a sustainability certificate will verify the fuel is produced from sustainable feedstocks.
The last year has shown there is higher risk of stability and compatibility issues with VLSFOs – how do biofuels compare?
Tried and tested biofuels do not appear to cause customers any more issues than fossil fuels. The issues experienced with VLSFOs have not been reported with their marine biofuels.
Are there any special tank cleaning requirements?
There are no reported problems regarding stability and compatibility when leftover fossil fuels remain in the tank. However, thorough cleaning of fuel tanks prior to use of biofuels will prevent operational problems caused by fossil fuel sediment entering the fuel system.
What do the engine makers say?
GoodFuels has carried out extensive testing of biofuels with the top five original equipment makers (OEMs). They are now very supportive of GoodFuels’ biofuels and additional OEMs are ratifying our products on a constant basis.
What is the future of biofuels?
Advanced marine biofuels are a fast-growing alternative fuel in the marine sector. July 2020 was a record month with biofuels representing 10% of all Rotterdam HFO volumes. We expect growth to continue for this low-sulphur ‘drop-in’ fuel which can be used in existing engines.
The shipping industry needs to keep its guard up. Shipowners and fuel purchasers should ensure that they are supplied only with sustainably sourced, high quality and stable products. GoodFuels can only vouch for the quality of their own products and regularly see bad quality biofuels from other suppliers with less stringent quality controls.
Poor quality-controlled biofuels can create operational issues and potential damage to main engines and generators. High repair costs not to mention the delays to cargo, commercial off-hire and lengthy disputes with charterers are all concerns. In rare cases de-bunkering may be required too.
How does NOx, calorific value and fuel consumption compare to fossil fuels?
The effect on NOx is still uncertain, but testing is underway together with clients, OEMs and classification societies. Calorific value can be lower than fossil fuels and therefore the fuel consumption may be slightly higher.
The IMO currently only considers GHG emissions from a tank-to-wake (TTW) perspective, where the potential for CO2 reductions from using biofuels is modest. Do you support the view that emissions should be considered from a well-to-wake (WTW) perspective?
Life cycle analysis guidelines have not been finalised by the IMO to fully credit the reduction of GHG on a WTW basis. However, this would be positive progress in our opinion.
The GHG reduction of our biofuels is calculated on a WTW basis as specified in the Renewable Energy Directive by the European Commission. However, the IMO presently calculate emissions for the Energy Efficiency Design Index (EEDI) and Energy Efficiency Existing Ship Index (EEXI) on a TTW basis. The EEDI encourages more efficient use of the same unit of energy. Fuels presently used in shipping contain carbon atoms, so the exhaust gas emissions give an indication of efficiency by comparing work done to CO2 emissions produced after combustion.
On a long-term basis, the IMO has targeted a 50% reduction of total GHG emissions between 2008 and 2050. This needs a different measurement approach. Hydrogen and ammonia are examples of fuels without a carbon atom. But the current production process means that more than 99% are produced using fossil fuels, such as methane. Therefore, zero CO2 emissions from the engine does not guarantee a zero-carbon production process. The WTW approach looks at the process right back to the source and is much fairer.
We understand that the IMO are working to incorporate the WTW approach in their “Reduction of GHG Emissions.” At GoodFuels we believe it’s only a matter of time before adjustments are made to the current emission calculation method.
Find out more
Find out more about GoodFuels here.
Read more about the changing landscape of fuels in our article ‘Fuels of the Future’ here.
Find our Decarbonisation shipping advice here.

